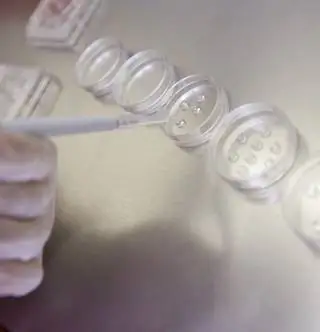
Состояние колбы Cambria можно проверить перед имплантацией

Большинство выкидышей вызвано аномалиями хромосомного числа эмбриона в случае любой беременности - естественной или искусственной. Чаще всего такой эмбрион даже не прикрепляется к матке, поэтому особое значение имеют обследования и скрининги, выявляющие подобные нарушения.
Существует новый метод преимплантационной генетической диагностики, скрининг анеуплоидии (PGD-A). Но что это? Как это работает? Это действительно работает? Это то, что мы искали.
Риск увеличивается с возрастом
После материнского возраста 37 лет резко возрастает доля эмбрионов с хромосомными аномалиями (анеуплоидиями) как в естественных, так и в искусственно зачатых эмбрионах. В этих случаях беременность обычно заканчивается выкидышем, либо новорожденные рождаются с серьезными генетическими нарушениями.
Нет необходимости объяснять, какую травму, психологическое и финансовое бремя они представляют для вовлеченных семей, поэтому совершенно понятно, что каждый хочет быть как можно более уверенным в том, что у него не будет выкидыша и что в конечном итоге у него будет здоровый малыш.

Эмбрионы можно фильтровать еще до имплантации
Метод ПГД-А (преимплантационная генетическая диагностика, скрининг анеуплоидии) позволяет еще до имплантации убедиться в том, что данный эмбрион не несет несовместимого с жизнью или вызывающего серьезные повреждения хромосомного расхождения. Во время этого метода из преэмбриона, которому всего 3-5 дней, берут несколько клеток и исследуют их, чтобы определить, несет ли он аномалию числа хромосом.
Во время этой чрезвычайно ранней стадии развития клетки еще не дифференцировались до такой степени, чтобы пре-эмбрион не смог регенерировать. Те преэмбрионы, у которых диагностирована анеуплоидия, не имплантируются, что позволяет избежать таких частых событий во время лечения бесплодия, которые обременяют пары как морально, так и финансово, например, тот факт, что беременность даже не наступает или часто заканчивается выкидышем.,

В пользу этого метода говорит и тот факт, что таким образом можно уменьшить количество преэмбрионов, подлежащих имплантации, поскольку опыт показывает, что большинство эмбрионов, считающихся подходящими, успешно прикрепляются, и здоровый ребенок рождается в окончание беспроблемной беременности. Однако при отсутствии этого метода практикуется имплантация как можно большего количества эмбрионов, поэтому многоплодная беременность чаще встречается при программах искусственного вскармливания, что, однако, увеличивает риск преждевременных родов и других проблем.
Результаты обнадеживают
Клиническая полезность метода наглядно подтверждается тем фактом, что аномалии числа хромосом обнаруживаются в среднем у 7-8 из 10 эмбрионов при тестировании. Технология, которая уже была внедрена во многих странах, была использована на более чем 500 000 эмбрионов по всему миру для повышения эффективности программ ЭКО.
А что против метода?
Многие люди беспокоятся о PGD или любом подобном методе и генетическом скрининге в целом, что они настраивают нас на будущее, подобное тому, которое мы видим в Гаттаке. Однако, с одной стороны, этот метод не подходит для предсказания того, как будет выглядеть ребенок, какого роста, насколько умным он будет во взрослом возрасте и т. д. Конечно, можно не сомневаться, что многие люди, если бы могли, были бы готовы потратить много денег, чтобы решить все, от курчавости волос своего ребенка до своих будущих интересов, но мы не всегда можем все подстроить. идиотам, потому что тогда мы теряем реальную пользу, а именно то, что мы можем избавить многие семьи от тяжелых болезней и значительно облегчить им рождение здорового ребенка. Мы должны помнить, что практически любую разработку можно использовать в плохих целях, поэтому решение не в запрете новых методов или препятствовании развитию генетических технологий, а в создании соответствующей правовой среды, не допускающей пола, цвета глаз и т.п.» «случайные» характеристики, на основании которых некоторые родители могут выбирать из эмбрионов, и что «производством» дизайнерских младенцев занимаются целые компании.
PGD-A уже доступен в Венгрии
Метод ПГД-А подвергся нападкам со стороны многих людей, считая его вредным «генетическим отбором», тогда как на самом деле это не что иное, как, например, скрининг на синдром Дауна, который является давно установленным практика, где в случае неблагоприятного исхода решение также остается за родителями. (В последнем случае, кроме того, должна решаться судьба уже существующей беременности, плода в несколько месяцев, а не десятиклеточного эмбриона пары, который еще не имплантировался.) профессиональные аргументы, трехлетнее расследование АНЦЗ окончательно установило, а затем в 2014 г.в своем ноябрьском постановлении он разъяснил законность использования этого метода в Венгрии. В настоящее время метод используется в одном институте, Институте репродукции человека Versys Clinics, но в будущем есть надежда, что круг тех, к кому могут обратиться пары с проблемами зачатия, если они хотят использовать этот метод, будет расширяться.